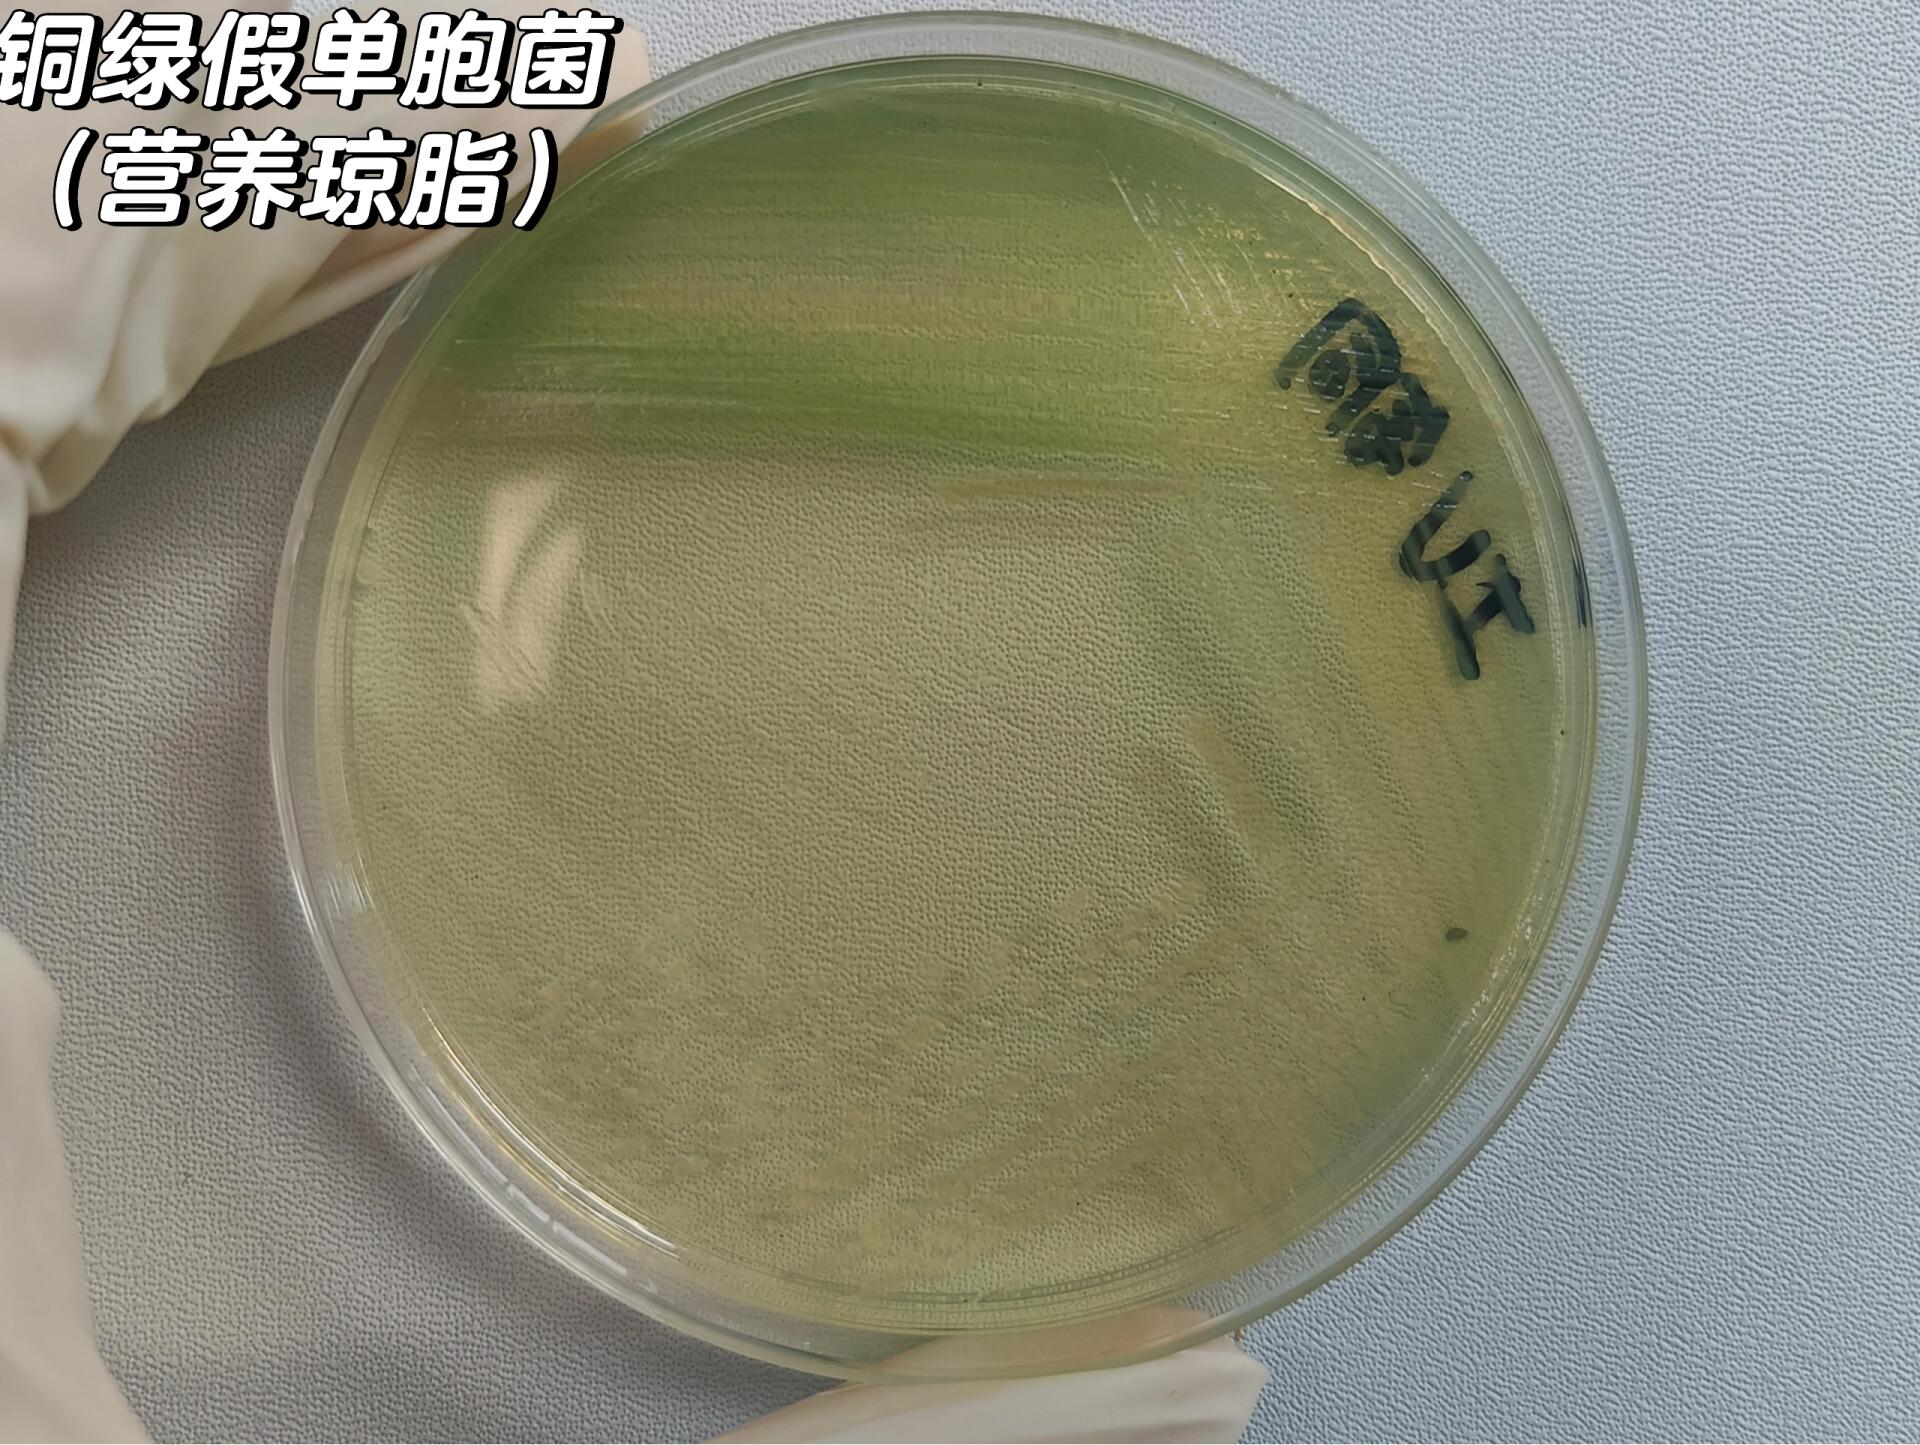
铜绿假单胞菌,黄杆菌
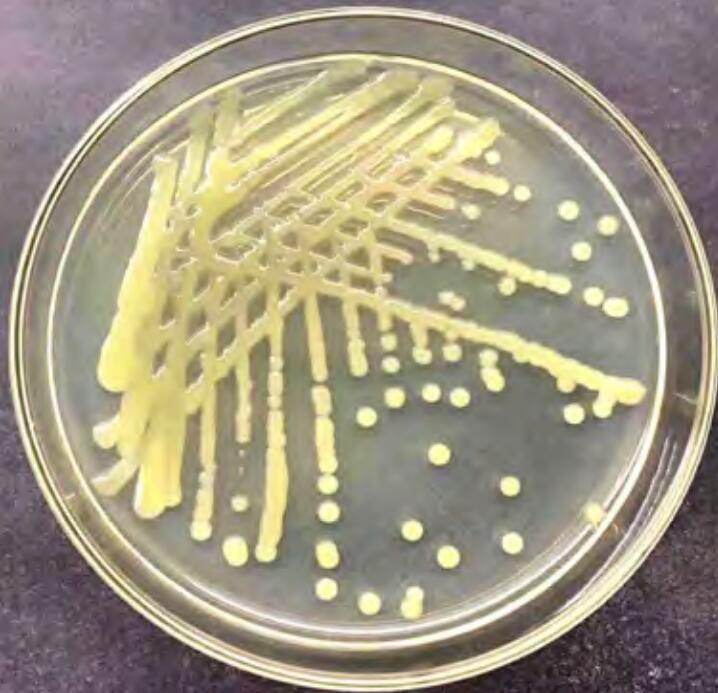
p data-id="suz1dyugrwfe">柠檬溃疡病是由野油菜黄单孢菌柑橘致病

黄单胞菌属

黄单胞菌属
图片尺寸909x529
黄蘑菇,别名又叫粉牛肝,黄牛肝,黄衣牛肝,黄色猪口茸,为真菌类担子菌
图片尺寸525x350
树生黄单胞菌(现2)
图片尺寸320x280
水稻细菌性褐条病是由水稻黄单胞菌引起的,主要症状为叶片出现褐色
图片尺寸1755x1280
铜绿假单胞菌,黄杆菌
图片尺寸1920x2551
一种单细胞黄色黏菌被送上太空没有大脑和眼睛却有惊人智力
图片尺寸600x527
终于锁定了引发"怪病"的罪魁祸首: 地毯草黄单胞柑桔致病变种
图片尺寸240x245
铜绿假单胞菌,黄杆菌
图片尺寸1920x1445
aureus)也称"金葡菌",隶属于葡萄球菌属,是革兰氏阳性菌代表,为一种
图片尺寸400x400
铜绿假单胞菌,黄杆菌
图片尺寸1920x1445
p data-id="suz1dyugrwfe">柠檬溃疡病是由野油菜黄单孢菌柑橘致病
图片尺寸718x693
这种黄色的菌类是什么?长在君子兰的花盆里,也不知道多久了
图片尺寸1600x1200
">黄蘑菇也叫 a target="_blank" href="/item/黄粉牛肝菌/10242178"
图片尺寸640x428
一种地毯草黄单胞菌噬菌体及其组合物试剂盒和应用
图片尺寸1755x1756
儿茶素对野油菜黄单胞菌的抑菌作用
图片尺寸3150x1075
土壤深黄单胞菌shbcc d71439非模式菌株营养肉汁琼脂 冻干物
图片尺寸800x800
康禾_病原菌_笔者
图片尺寸936x624
一株墨西哥假黄单胞菌及其在促进杂交构树繁育中的应用
图片尺寸1206x1097
p>番茄疮痂病是由野油菜黄单胞菌疮痂致病变种引起的,发生在 a
图片尺寸516x398
痰标本里面的嗜麦芽窄食单胞菌,黄黄的,阴杆,48小时培养菌落有猫眼
图片尺寸1080x1439